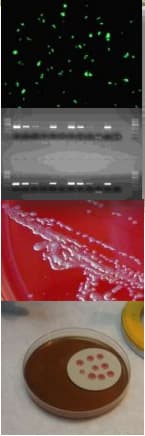

Enfermedades venéreas que afectan la reproducción
Publicado: 10 de noviembre de 2017
Fuente: Marcelo Fort. INTA

TORO
La transmisión es exclusivamente a través del coito.

La infección no causa ninguna lesión clínica aparente, a excepción de una inflamación en la primera etapa.


- Los toros mas viejos son más susceptibles.
- La cantidad de microorganismos en la cavidad prepucial es fluctuante.
- La población de microorganismos aumenta con el descanso sexual previo.
VACA
Vacas y vaquillonas que no han tenido contacto sexual previo son altamente susceptibles

La infección se produce en la vagina en donde los microorganismos se reproducen para luego invadir útero

- Si la fertilización se produce, HAY UN RETRASO EN EL CELO, debido a la inflamación producida como respuesta.
- La infección es AUTOLIMITANTE en la hembra.

- El aborto puede ser temprano 1-3 semanas (pasa desapercibido) o tardío, a las 8-18 semanas.
- La infección puede persistir en vagina de 1 a 5 meses.

Síntomas de la enfermedad en el rodeo
- Durante el servicio el desgaste excesivo de toros y la repetición de celos.
- Al tacto rectal la aparición de un número importante de vientres vacíos y la presentación de muchas preñeces correspondientes al período final del servicio

- Diferencias entre los porcentajes de preñez al tacto y los porcentajes de parición.
- En servicios continuos hay un marcado aumento del intervalo entre partos.

Diagnóstico
Recolección de muestras en el macho
- Lavaje
- Hisopado
- Raspaje
- Aspiración seca

Recomendaciones para el muestreo
- Cantidad óptima de raspajes 3-4. Mínimo 2 negativos consecutivos.
- Intervalos entre muestreos de 7-10 días


Diagnóstico Laborarorio
Medios de transporte
Tritrichomonas
- SST
- Leche desc. + AB
- Medios de cultivo + AB
Campylobacter
- SST formolada 0.5 – 1 %
- Medios de transporte enriquecidos con atmósfera

Métodos de diagnóstico para Trichomonas foetus
- Cultivo
- Serología (IHA, ELISA)
- PCR y qPCR

Resultados PCR en muestras positivas a cultivo de Trichomonas en Laboratorios en Red-2014

Resultados PCR en muestras positivas a cultivo de Trichomonas en Laboratorios en Red-2015

Tetratrichomonas de toros vírgenes


Trichomonas foetus. Evaluación de la protección conferida por dos vacunas diferentes.(Campero y col.)

Efecto de la TGB sobre la tasa de parición (Clark y col, 1983)

Efecto de la TGB sobre la tasa de parición (Clark y col, 1983)

Campilobacteriosis Genital Bovina

Genero Campylobacter

- Reino: Bacteria
- Filo: Proteobacteria
- Clase:Epsilon proteobacteria
- Orden: Campylobacterales
- Familia: Campylobacteraceae
- Género:Campylobacter
- Especies:
- C. coli
- C. concisus
- C. curvus
- C. faecalis
- C. fetus
- C. gracilis
- C. helveticus
- C. hominis
- C. hyointestinalis
- C. insulaenigrae
- C. jejuni
- C. lanienae
- C. lari
- C. mucosalis
- C. rectus
- C. showae
- C. sputorum
- C. upsaliensis
Campylobacter: Caracteristicas generales
- Microaerófilo
- Gram (-)
- Forma de S
- 0.2-0.8 X 0.5-5 u
- Flagelo polar
- Tº 25-37ºC
- S-layer Proteinas – 8 sap

Clasificación histórica y nomenclatura de subespecies de Campylobacter fetus

Campylobacter fetus subespecie veneralis
- Campilobacteriosis Genital Bovina (CGB)
- Restringido al tracto genital bovino
- Infertilidad temporaria. Falla de implantación y secundaria endometritis. Aborto es menos común
- La infección es aguda, puede convertirse en crónica pero casi siempre es autolimitante ( 4-5 meses)
- La ruta de transmisión es por servicio natural o IA con semen proveniente de toros infectados.
- Presentación: infecciones subclínicas, baja en las tasas de parición. “Quiet profit taker”
Campylobacter fetus subespecie veneralis biovar intermedius
- Este biovar muestra características similares a Cfv
- La literatura es contradictoria en cuanto a si este biovar puede colonizar solo el tracto reproductivo o ambos (reproductivo e intestinal).
- Para el diagnóstico y medidas de control son las mismas que en Cfv.
Cepas de Campylobacter aisladas en Argentina

Lo que dice el manual terrestre de la OIE sobre la CGB
- La más importante medida en el control de CGB es prevenir la infección, a través de la detección y eliminación de toros infectados.
- Esto requiere de programas sanitarios con monitoreo permanente de toros.
- Las vacunas pueden ser parte de los programas, sin embargo hay mucha información respecto a la baja calidad de las vacunas comerciales.
Campylobacter fetus subespecie fetus
- Causa abortos esporádicos en bovinos.
- Los ovinos son el reservorio primario de Cff. Aunque puede ser aislado de diferentes especies (B-C-P-E).
- Cff puede ser aislado del tracto intestinal y vesícula biliar de bovinos sanos. Portadores
- La ruta de transmisión es oral, forraje contaminado con heces, fetos abortados, descargas.
Principal hospedador e importancia clínica de las subespecies de Campylobacter

Métodos de diagnóstico para campylobacter foetus

CAMPYLOBACTER
- Inmunofluoresc.
- Cultivo
- PCR
- ELISA
- Mucoaglutinación
DIAGNÓSTICO


IF vs PCR

Características diferenciales de especies de Campylobacter que podrían ser aisladas del tracto genital bovino y fetos abortados

Diagnóstico
- Esmegma prepucial obtenida mediante raspado
- Medios de transporte/cultivo: Lander y TTE
- Técnicas detección/identificación: IFD, Cultivo, PCR
- Cultivo: Baja sensibilidad: i) escasa viabilidad del germen fuera del hospedador, ii) gran sensibilidad a las fluctuaciones de Tª, iii) Contaminación heces y comensales, iiii) sensible a determinados antibióticos.


Secuencia en el procesamiento de muestras





Ensayo de Vacunación contra CGB

Ensayo de vacunación contra CGB (2)

Pocos aislados de C. fetus veneralis

Isolation rates of Campylobacter fetus subsp venerealis from bovine preputial samples via passive filtration on nonselective medium versus selective medium, with and without transport médium (2013) Chaban, Bonnie; Guerra, Alvaro Garcia; Hendrick, Steven H.; et ál.. AMERICAN JOURNAL OF VETERINARY RESEARCH, 74-8, 1066-1069
El efecto de la CGB sobre la distribución de la parición

Desarrollo de una q-PCR para el diagnóstico conjunto de Tritrichomonas foetus y Campylobacter foetus veneralis en muestras prepuciales.


Ventajas de la q-PCR
- La Q-PCR permite, empleando un fluorocromo de unión inespecífica (SYBR Green; Go Taq Green), identificar fragmentos amplificados de DNA concretos a partir de la temperatura de fusión ( Tm, melting temperature)
- Es específica para el fragmento amplificado que se está buscando; y cuyos resultados son obtenidos a partir de la observación de la curva de disociación de las muestras de DNA analizadas.9
- Ello permite, a diferencia de PCR convencional, prescindir del posterior empleo de técnicas de electroforesis para la visualización de los resultados de todas las muestras

- Tb. esta técnica lleva a la obtención de resultados más rápidos, y/o en el menor gasto de reactivos empleados en las técnicas de electroforesis.
- Permite el diagnóstico de ambas enfermedades es una única muestra.

Métodos

Resultados: Curvas de disociación de Trico y Campy

Resultados: Muestras con igual cantidad de ADN de Trico y Campy

Resultados: Muestras con diferencias de una dilución base 10.

Resultados: Muestras con diferencia de dos diluciónes base 10.

Test de concordancia para Campylobacter

Test de concordancia para Trichomonas foetus

Test de concordancia para Campylobacter y T. foetus

Valores CT promedios:
- Muestras positivas a Campy(72) : 24.8
- Muestras Positivas a Trico (41): 24.6
- Muestras negativas: 37.7
- Muestras Positivas a Trico y a Campy(5): 23.6

Especificidad Trichomonas

Especificidad a Campylobacter:

Diagnóstico e identificación de Campylobacter fetus veneralis en el mundo. (van Bergen, M)

Diagnóstico e identificación de Campylobacter fetus veneralis en el mundo. (van Bergen, M)

Diagnóstico e identificación de Campylobacter fetus veneralis en el mundo. (van Bergen, M)

Prevalencia de Campylobacter en toros de 3 estados del norte de Nigeria (Mai et al. , 2013)

Diagnóstico y manejo de la CGB en un rodeo de carne.(Truyers, I , 2014)

PATOGENIA Y EPIDEMIOLOGIA DE UN RODEO BOVINO INFECTADO NATURALMENTE CAMPYLOBACTER FETUS VENEREALIS INTERMEDIO
MATERIALES Y MÉTODOS
Se utilizó un lote de 15 vaquillonas de primer servicio, 3 vacas y 2 toros infectados naturalmente con Cfvi, diagnosticados por Cultivo, PCR y AFLP
RESULTADOS
- Los 2 toros fueron positivos a las tres técnicas (IF en PBS, IF en TTE y cultivo en placa) durante todo el tiempo de duración del ensayo.
- 9/15 (60%) vaquillonas y 2/3 (66%) vacas fueron positivas a alguna técnica en algunos de los diferentes muestreos.
- 8 (53%) de las vaquillonas quedaron preñadas y 4 vaquillonas registraron abortos al final del ensayo (4 meses).
- 3/3 (100%) vacas concluyeron la preñez. 4/15 ( 27%) vaquillonas concluyeron la preñez
Plan para el Control y erradicación de las enfermedades venéreas en bovinos de la PROVINCIA DE LA PAMPA

Las enfermedades venéreas en la Provincia de La Pampa.

Porqué las enfermedades venéreas persisten en los rodeos de cría?
- Por el desconocimiento generalizado de la influencia negativa que sobre la fertilidad de los rodeos ejercen estas enfermedades.
- Por el tipo de manejo extensivo de las explotaciones de cría
- Por la deficiente información sobre los porcentajes reales de preñez y parición existentes.
- Por la falta de legislación que evite la venta y comercialización de animales portadores y que proteja a los productores que controlan las enfermedades venéreas en sus rodeos.
La inexistencia de programas que lleven al control y erradicación de estas enfermedades.
Los programas voluntarios y la adopción de tecnología en distintos estratos de productores

Propósitos
- Aumentar la eficiencia reproductiva de los rodeos bovinos provinciales.
- Lograr una producción ganadera sanitariamente adecuada a los requerimientos
- Mejorar la rentabilidad del sector agropecuario aumentando la producción de terneros.
2. Objetivos generales
- Lograr que el 100% de los toros existentes en la Provincia sean anualmente revisados de acuerdo a las pautas fijadas por el Programa.
- Controlar y erradicar la Campilobacteriosis y la Tricomonosis Genital Bovina.
- Evitar el riesgo de transmisión.

Etapas de desarrollo del plan

Comunicación y difusión

Estudios de prevalencia y análisis de riesgos en el inicio del Programa de Control de Enfermedades Venéreas
Años 2006 y 2007

Enfermedades venereas en RODEOS al inicio del Programa de control

Enfermedades venéreas en TOROS al inicio del Plan de control

Enfermedades venéreas en RODEOS al inicio del Plan de control

Plan provincial para el control y erradicación de las enfermedades venéreas en bovinos de la Provincia de La Pampa.
- Factores de riesgo para enfermedades venéreas






Evolución del Programa de Control de Enfermedades venéreas durante el período

Porcentaje de toros controlados anualmente

Resultados del programa para el control de las enfermedades venéreas en bovinos de La Pampa

Resultados del programa para el control de las enfermedades venéreas en bovinos



Rodeos Positivos a CGB

Porcentaje de Unidades productivas que volvieron a tener Tricomonosis



9264 toros fueron detectados positivos enfermos desde el año 2007 al 2016”.

2497 rodeos controlaron las enfermedades venéreas


Para el logro de los objetivos es necesario:

La obligación de la eliminación de los toros que resulten positivos a enfermedades venereas
Principales causas de pérdidas reproductivas en el ganado bovino en La Pampa Casuística 2004-2011


Tratamientos contra Trichomoniasis

Metodos

Identificación de aislados

Identificación bacteriológica a partir de MALDI- Biotyper

Aislados de Muestras Prepuciales

Inmunofluorescencia de los Aislados

qPCR- Resultados de Aislados

Temas relacionados:
Autores:

Recomendar
Comentar
Compartir
16 de enero de 2018
Excelente articulo Dr.Fort sobre estas enfermedades venéreas que tanta pérdida producen en el rodeo bovino argentino.
Muy útil la descripción de todos los métodos diagnosticos , sobre todo los referidos a campylobacteriosis.
Solo agregaría respecto a los síntomas de Tricomoniasis en el rodeo, la detección al realizar los tactos rectales de rutina, la aparición de las típicas piometras , que en tactos realizados " a la ligera" , pueden pasar desapercibida al semejar preñeces de 60 dias . Inconfundible contenido purulento "sin olor" y que con simple microscopio de campo, se diagnostica en la manga....
Recomendar
Responder
Recomendar
Responder
Recomendar
Responder

¿Quieres comentar sobre otro tema? Crea una nueva publicación para dialogar con expertos de la comunidad.